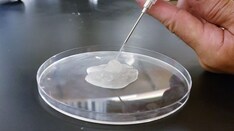
'Cool' Way of Eradicating Fat Has Potential for Treating Several Medical Conditions

BERLIN — European guidelines now in press for the diagnosis and treatment of body dysmorphic disorder (BDD), a condition defined largely by abnormal perceptions about — and behavior surrounding personal appearance, were outlined in a late-breaker presentation at the annual Congress of the European Academy of Dermatology and Venereology.
The development of guidelines for BDD, a disorder familiar to many clinical dermatologists, is intended as a practical tool, according to Maria-Angeliki Gkini, MD, who has appointments at both Bart’s Health NHS Trust in London and the 401 General Army Hospital in Athens.
"BDD is a relatively common disorder in which the patients are preoccupied with a perceived defect or defects," Dr. Gkini explained. "This affects them so intensely that it affects their mental health and their quality of life."
In the DSM-5, published by the American Psychiatric Association, BDD is specifically defined as a preoccupation with "one or more perceived defects or flaws in physical appearance that are not observable or appear slight to others." But Dr. Gkini said that BDD can also develop as a comorbidity of dermatological disorders that are visible.
These patients are challenging because they are difficult to please, added Dr. Gkini, who said they commonly become involved in doctor shopping, leaving negative reviews on social media for the clinicians they have cycled through. The problem is that the defects they seek to resolve typically stem from distorted perceptions.
BDD is related to obsessive-compulsive disorder by the frequency with which patients pursue repetitive behaviors related to their preoccupation, such as intensive grooming, frequent trips to the mirror, or difficulty in focusing on topics other than their own appearance.
The process to develop the soon-to-be-published guidelines began with a literature search. Of the approximately 3,200 articles identified on BDD, only 10 involved randomized controlled trials. Moreover, even the quality of these trials was considered "low to very low" by the experts who reviewed them, Dr. Gkini said.
One explanation is that psychodermatology has only recently started to attract more research interest, and better studies are now underway, she noted.
However, because of the dearth of high quality evidence now available, the guideline development relied on a Delphi method to reach consensus based on expert opinion in discussion of the available data.
Consensus reached by 17 experts
Specifically, 17 experts, all of whom were members of the European Society for Dermatology and Psychiatry proceeded to systematically address a series of clinical questions and recommendations. Consensus was defined as at least 75% of the participants strongly agreeing or agreeing. Several rounds of discussion were often required.
Among the conclusions, the guidelines support uniform screening for BDD in all patients prior to cosmetic procedures. In identifying depression, anxiety, and distorted perceptions, simple tools, such as the Patient Health Questionnaire might be adequate for an initial evaluation, but Dr. Gkini also recommended routinely inquiring about suicidal ideation, which has been reported in up to 80% of individuals with BDD.
Other instruments for screening that can be considered include DSM-5 criteria for BDD and the Body Dysmorphic Disorder Questionnaire–Dermatology Version, which might be particularly useful and appropriate for dermatologists.
One of the reasons to screen for BDD is that these patients often convince themselves that some specific procedure is needed to resolve the source of their obsession. The goal of screening is to verify that it is the dermatologic concern, not an underlying psychiatric disorder that is driving their search for relief. The risk of dermatologic interventions is not only that expectations are not met, but the patient’s perception of a failed intervention "sometimes makes these worse," Dr. Gkini explained.
Collaboration with psychiatrists recommended
The guidelines include suggestions for treatment of BDD. Of these, SSRIs are recommended at high relative doses, according to Dr. Gkini. Consistent with the consensus recommendation of collaborating with mental health specialists, she said that the recommendations acknowledge evidence of greater benefits when SSRIs are combined with psychotherapy.
Katharine A. Phillips, MD, professor of psychiatry at Weill Cornell Medicine, New York, has been conducting BDD research for several years and has written numerous books and articles about this topic, including a review in the journal Focus. She cautioned that, because of a normal concern for appearance, BDD is easily missed by dermatologists.
"For BDD to be diagnosed, the preoccupation with a nonexistent or slight defect in appearance must cause clinically significant distress or impairment in functioning," she said in an interview. "This is necessary to differentiate BDD from more normal and common appearance concerns that do not qualify for the diagnosis."
She specified that patients should be considered for cognitive-behavioral therapy rather than psychotherapy, a generic term that covers many forms of treatment. She said that most other types of psychotherapy "are probably not effective" for BDD.
Dr. Phillips highly endorsed the development of BDD guidelines for dermatologists because of the frequency with which physicians in this specialty encounter BDD — and believes that more attention to this diagnosis is needed.
"I recommend that dermatologists who have a patient with BDD collaborate with a psychiatrist in delivering care with an SSRI," she said. "High doses of these medications are often needed to effectively treat BDD."
Dr. Gkini reported financial relationships with AbbVie, Almirall, Celgene, Eli Lilly, Janssen, LEO, Novartis, Sanofi, and Regenlab. Dr. Phillips reported no relevant financial relationships.
This article originally appeared on MDedge.com, part of the Medscape Professional Network.
Credits:
Lead image: Microgen/Dreamstime
© 2023 Frontline Medical Communications Inc.
Cite this: Body Dysmorphic Disorder: Diagnosis Guidelines to Be Published in Europe - Medscape - Nov 08, 2023.

Comments